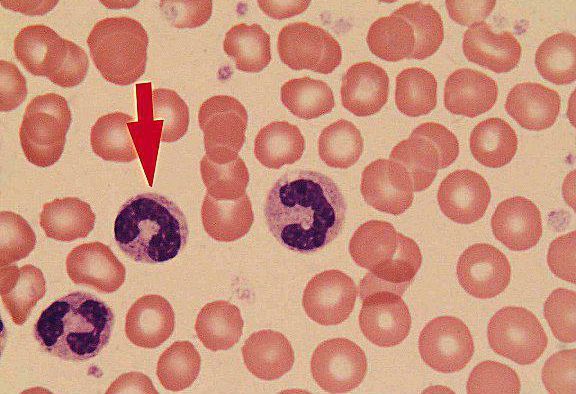
Если палочкоядерные нейтрофилы 0 у взрослого – о чем это говорит. Почему у ребенка повышены сегментоядерные и палочкоядерные нейтрофилы: причины высоких показателей в анализе крови
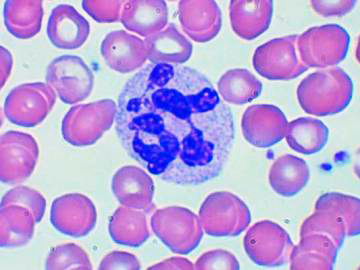
Если палочкоядерные нейтрофилы 0 у взрослого – о чем это говорит. Почему у ребенка повышены сегментоядерные и палочкоядерные нейтрофилы: причины высоких показателей в анализе крови
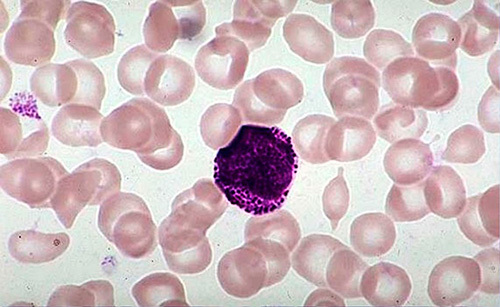
Если палочкоядерные нейтрофилы 0 у взрослого – о чем это говорит. Почему у ребенка повышены сегментоядерные и палочкоядерные нейтрофилы: причины высоких показателей в анализе крови
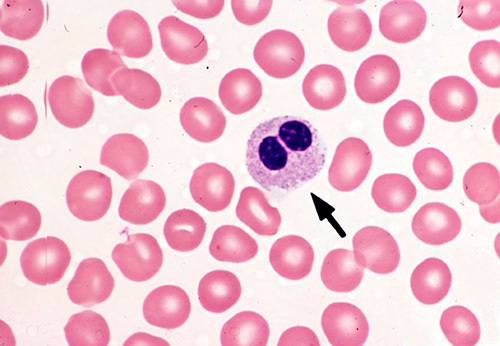
Если палочкоядерные нейтрофилы 0 у взрослого – о чем это говорит. Почему у ребенка повышены сегментоядерные и палочкоядерные нейтрофилы: причины высоких показателей в анализе крови
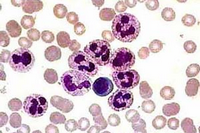
Если палочкоядерные нейтрофилы 0 у взрослого – о чем это говорит. Почему у ребенка повышены сегментоядерные и палочкоядерные нейтрофилы: причины высоких показателей в анализе крови

7 миллионов нейтрофилов рождаются каждую минуту, чтобы максимально защитить организм от атаки вредоносных бактерий. Эти клетки обладают уникальными свойствами, и ценой своей жизни спасают человека от чужеродных микробов.
Повышенный уровень нейтрофилов (нейтрофилез)

Фагоцит поглощает бактерию
Основной функцией нейтрофилов является ограждение организма от всевозможных болезнетворных частиц. Они моментально реагируют на проникновение чужеродного микроорганизма, поглощают его и переваривают. Сами нейтрофилы после этого погибают, выделяя при этом большое количество специфичных веществ, которые разрушают оставшиеся бактерии.
Нейтрофилы — это самая многочисленная группа лейкоцитов, показатели их уровня обычно определяются при стандартном клиническом анализе крови. Если значения превышают норму, в организме происходит воспалительный процесс. Это состояние называется нейтрофилез. В зависимости от степени повышения, можно определить насколько обширным является воспаление.
Исследование количества нейтрофильных клеток включает в себя измерение их общего числа в единице крови, а также процентное соотношение к общему числу лейкоцитов.
Значения выше нормы для взрослых:
- в абсолютном количестве — > 6,5 * 109/л;
- в процентном соотношении — > 75%.
Причины нейтрофилеза у взрослых

Нейтрофилез — верный спутник бактериальной инфекции
Рост иммунных клеток указывает на ответную реакцию организма по отношению к болезнетворным микробам. Обнаружение повышенного значения нейтрофилов указывает на следующие причины:
- заболевания, вызванные бактериями: пневмония, ангина, отит, гайморит, дизентерия, туберкулёз, дифтерия, лимфоретикулёз, остеомиелит, столбняк, сифилис, гонорея и другие;
- некроз тканей, образующийся в следствии гангрены, обширных ожогов, сердечно-сосудистых заболеваний;
- грибковые заболевания: микоз, кандидоз, лишай;
- онкологические заболевания различных органов;
- сахарный диабет;
- воспалительное поражение кожных покровов;
- анемия;
- патологии кровеносной системы;
- интоксикация, в том числе алкогольными напитками.
Сегментоядерные нейтрофилы повышены у взрослых

Развитие нейтрофилов
Нейтрофилы зарождаются в костном мозге и проходят стадии развития от миелобласта до палочкоядерной, а затем сегментоядерной клетки. Зрелые клетки содержат ядро, которое состоит из сегментов, связанных между собой нуклеопротеидными нитями. В кровяном русле взрослого человека составляют около 70% от числа всех лейкоцитов.
Сегментоядерные нейтрофилы живут около 14 суток, после чего разрушаются в печени и селёзенке. Если клетки сталкиваются с патогенными частицами, то в борьбе с ними погибают раньше.
Ускоренная гибель клеток провоцирует активное зарождение новых нейтрофилов. Этот процесс продолжается до полного восстановления повреждённых микробами тканей.
Поэтому повышенное количество указывает на воспалительный процесс в организме либо на его наличие в недавнем прошлом.
Обнаружив повышенные значения сегментоядерных нейтрофилов, врач назначит дополнительные обследования для выяснения причины. Факторами, вызвавшими рост зрелых клеток, могут быть воспалительные явления, инфекционные процессы, злокачественные образования, заболевания сердечно-сосудистой и дыхательной систем.
Показатель выше нормы для взрослых — > 72%.
Палочкоядерные нейтрофилы повышены у взрослых
Палочкоядерные нейтрофилы в мазке крови
Незрелый нейтрофил обладает ядром, напоминающим по внешнему виду палочку, откуда и пошло его название. Палочкоядерные клетки проходят стадию дозревания в костном мозге, поэтому в кровяном русле взрослого человека их количество невелико. В среднем они составляют от 3 до 5% от всех видов иммунных клеток.
В отличие от сегментоядерных, незрелые клетки не обладают всеми инструментами для борьбы с вредоносными микроорганизмами. Их основная задача — развиваться до следующего, зрелого уровня. Рост их количества в единице крови означает, что происходит активное производство новых нейтрофилов.
Повышение единиц незрелых клеток называется сдвигом лейкоцитарной формулы влево. Это характерный показатель, который означает в большинстве случаев ухудшение состояния пациента. Например, если на фоне гриппа обнаруживается рост палочкоядерных нейтрофилов, речь идёт о присоединении бактериальной инфекции.
Поэтому диагностика палочкоядерных клеток является обязательной при терапии, послеоперационном периоде, прекращении курса медицинских препаратов. Повышенный показатель укажет на возникновение осложнения.
Значение выше нормы для взрослых — > 6%.
Как выявить нейтрофилез?

Основа диагностики нейтрофилеза — клинический анализ крови
Уровень нейтрофилов диагностируется на основе развёрнутого клинического анализа крови. Перед анализом на уровень нейтрофилов необходимо отказаться от пищи за 8 часов до изъятия крови, исключить физическое перенапряжение, алкогольные напитки и медикаменты.
Значения выше нормы свидетельствуют о наличии нейтрофилеза. Данную патологию разделяют на 3 стадии, в зависимости от уровня превышения нормы.
- Абсолютное количество нейтрофилов составляет до 10 * 109/л — воспаление умеренного характера, локализованное в одном очаге;
- Численность клеток диагностируется от 10 до 20 * 109/л — выраженный нейтрофилёз при более сильном воспалительном процессе, распространившимся далее одного очага;
- Уровень нейтрофилов в единице крови определяется от 20 до 60 * 109/л — тяжёлая стадия, свидетельствующая об обширном поражении организма в целом.
- Если в бланке с результатами анализа указано только процентное соотношение, можно вычислить абсолютный показатель по формуле:
- Относительный показатель * число лейкоцитов / 100.
- Если показатель в процентах равен 68, а лейкоцитов всего 7 * 109/л, то 68 * 7 / 100 = 4,76.
Что может повлиять на результаты исследования?

Прием пищи накануне теста может спровоцировать нейтрофилез
Умеренный нейтрофилёз указывает не только на патогенные процессы, но и отражает некоторые физиологические состояния. Небольшой рост клеток может быть спровоцирован:
- беременностью,
- повышенной физической нагрузкой,
- стрессом,
- обильным приёмом пищи.
Ряд лекарственных средств также вызывает рост числа нейтрофилов. Если приём медицинских препаратов невозможно отменить перед сдачей анализа, необходимо обязательно сообщить об этом врачу.
Лекарства, повышающие уровень нейтрофилов:
- Ацетилхолин-хлорид,
- Хлорпропамид,
- Гепарин,
- Гистамин,
- Норэпинефрин,
- все кортикостероидные лекарства,
Как понизить уровень нейтрофилов у взрослых?

Причину нейтрофилеза должен устанавливать специалист
Если число нейтрофилов возросло, значит иммунная система нуждается в таком количестве клеток для угнетения патологических процессов в организме. Поэтому специально снижать уровень нейтрофилов не нужно. Необходимо найти причину их повышения, исключить её, тогда число клеток иммунитета снова придёт в норму.
Наиболее частым фактором роста нейтрофилов является бактериальное инфицирование. В зависимости от заболевания, пациенту будет назначен курс антибиотиков узкого либо широкого спектра. Для лечения грибковых инфекций используются различные противогрибковые средства, в случае их повторения — антибиотики.
Опасность повышенного уровня нейтрофилов в крови

Нейтрофилез без внимания чреват осложнениями
Рост числа нейтрофилов не всегда сопровождается выраженными симптомами. Человек может считать себя абсолютно здоровым, а обнаружить отклонение от нормы только на бланке с результатами анализов. Это может означать, что в организме протекает скрытая инфекция. Если не предпринимать меры, то воспалительный процесс захватит более обширные участки.
Злокачественные и доброкачественные опухоли проявляются повышенным уровнем нейтрофилов. Если на протяжении длительного периода число клеток значительно превосходит норму, врач может заподозрить у пациента онкологическую природу патологии.
При беременности небольшой рост нейтрофилов относится к показателям нормы. Но слишком высокие значения могут привести к выкидышу, так как нейтрофилы воспринимают плод как чужеродный организм в теле женщины.
Профилактика

Профилактика нейтрофилеза — залог хорошего здоровья
Для того, чтобы нейтрофилам не пришлось усиленно бороться с болезнетворными бактериями, нужно помочь организму избежать проникновения болезнетворных микробов.
- Ягоды, фрукты, овощи употреблять только чистыми. Мясо, рыба, молоко должны быть обработаны термически правильно.
- Необходимо соблюдать личную гигиену: тщательно мыть руки, чистить зубы, следить за чистотой предметов обихода.
- Жилое помещение ежедневно должно проветриваться, влажную уборку нужно проводить регулярно.
- Необходимо избегать контакта с больными людьми.
- Раны, ссадины следует продезинфицировать и защитить от внешней среды при помощи бинта либо пластыря.
Нормы содержания нейтрофилов в крови и какие функции они выполняют
Нейтрофилы являются одной из самых многочисленных групп лейкоцитов или клеток белой крови, входящих в ее состав. Их приоритетной задачей является борьба с бактериями и вирусами в крови и тканях человеческого тела. По своей сути нейтрофилы — это защитники.
Созревание и типы нейтрофилов
Образование нейтрофила проходит в несколько этапов. Первоначально он всегда зарождается в красном костном мозге, а после проникает в плазму. Через определенный промежуток времени он делится на сегменты. После полноценного формирования примерно через промежуток от 2 до 5 часов он проникает в стенки капилляров в органах человека.

Палочкоядерные нейтрофилы — это незрелые клетки
Главной классификацией нейтрофилов является разделение по зрелости. Виды по данному показателю:
- Палочкоядерные нейтрофилы. Они являются функционально незрелыми клетками крови, обладают ядром, напоминающим при визуальном рассмотрении палочку. Кроме этого, у них отсутствует сегментированное ядро;
- Сегментоядерные нейтрофилы. Представляют собой зрелые клетки, которые обладают ярко выраженным сегментированным ядром. Нейтрофилы данного вида являются основной массой лейкоцитов человеческой крови при отсутствии каких-либо болезней. Приблизительное их количество варьируется и составляет от 40 до 70%.
Норма нейтрофилов в крови
Нейтрофилы, норма которых как у мужчин, так и у женщин одинакова, по показателям колеблются лишь в зависимости от возраста и особенностей организма. Общий анализ крови не имеет графы «нейтрофилы», соответственно рассматриваются отдельно два показателя:
- анализ сегментоядерных нейтрофилов;
- палочкоядерные нейтрофилы.
Эти показатели помогают врачам понять, имеется ли воспалительный процесс, инфекционные заболевания. Для сегментоядерных нейтрофилов норма должна быть:
- от 0 до 12 месяцев — 10-40%;
- от 1 года до 6 лет — 20-45%;
- от 6 до 15 лет — 30-60%;
- от 16 до 20 — 35-65%.
Небольшое различие показателя нормы есть у взрослых мужчин и женщин, а именно 40-70% и 50-80% соответственно.
Сегментоядерные нейтрофилы, норма которых варьируется в пределах от 1,8 до 6,5 миллиардов единиц на 1 литр крови, составляет примерно 50-70% от общего количества.
Палочкоядерные нейтрофилы у новорожденных детей составляют 5-12%, в возрасте от 1 недели до 12 лет количество варьируется от 1 до 4%. У взрослого человека — от 1-4% от общего числа.
Нередко бывает так, что сегментоядерные нейтрофилы понижены, причины этой патологии расписаны в статье на нашем сайте.
Сегментоядерные нейтрофилы — созревшие клетки, обладающие сформированным ядром
Важно! Повышение нейтрофилов означает наличие воспаления в организме или инфекции. Врач сразу же определяет серьезность заболевания и место очага.
Нейтрофилы, показатели которых в норме, выполняют три важные для человеческого организма функции. За что отвечают данные лейкоциты? Давайте разберемся. Их главными функциями являются:
- защита человеческого организма;
- захват вирусов и бактерий;
- уничтожение «врагов».
Для определения количества нейтрофилов делается общий анализ крови. Именно он отражает все нужные показатели. Кровь берется из пальца в утреннее время.
Важно! Перед сдачей крови на нейтрофилы нельзя употреблять пищу, так как данные могут быть искажены.
Токсическая (токсогенная) зернистость нейтрофилов
Токсическая зернистость нейтрофилов, причины которой могут быть различны, проявляется преобразованиями клеток дегенеративного характера, возникающими из-за имеющихся патологий:
- болезней инфекционного характера;
- сбоев в процессах кроветворения;
- воздействия химических веществ;
- влияния радиации.
Ранее мы уже писали о симптомах гиперкалиемии и рекомендовали добавить эту статью в закладки.
Изменения могут затронуть как ядро, так и цитоплазму. При влиянии раздражителя осуществляется коагуляция белка цитоплазмы, это и есть признаки токсической грануляции. Это явление находит отражение в сдвиге лейкоцитной формулы. Обнаружение этого процесса, когда проводится исследование нейтрофилов, означает прогрессирование патологии.
Пельгеровская аномалия нейтрофилов
Нейтрофилы в крови, как и иные клетки, могут подвергаться различным патологическим процессам. Одним из них является пельгеровская аномалия. Она характеризуется изменением крови и наследуется по доминантному принципу.
Главным проявлением патологии является формирование пельгеровских лейкоцитов, в которых нарушена сегментация: ядро старое, а форма юная. Ядро при этом может иметь форму эллипса, боба, а также оно укорочено. Кроме этого, возможно формирование ядра с перетяжкой по центру.
Важно! Реакции людей, имеющих данную аномалию, не отличаются от тех, у кого она отсутствует. Все функции такие нейтрофилы способны выполнять в полной мере.
Нейтрофилы играют важную роль в организме человека и являются маячками наличия каких-либо заболеваний, а также защитниками от вирусов, инфекций и бактерий.
Рекомендуем изучить похожие материалы:
- 1. Система гемостаза: зачем сдавать анализ на свёртываемость крови
- 2. Аутоиммунная гемолитическая анемия у детей: чего не хватает и как проявляется
- 3. Как подобрать диету по группе крови: худеем вместе
- 4. Понизился уровень базофилов у взрослых: как лечить базофилию
- 5. Причины повышения или понижения нейтрофилов в анализе крови у детей?
- 6. Функции и возможные причины патологий сегментоядерных нейтрофилов
- 7. О чём говорит высокий уровень нейтрофилов и опасно ли это?
Палочкоядерные нейтрофилы
Палочкоядерные нейтрофилы – это компоненты крови, которые входят в группу гранулоцитов и отвечают за корректную работу иммунной системы. Изменение количества клеток в меньшую или большую сторону будет свидетельствовать о развитии патологического процесса в организме.
Определить количество палочкоядерных нейтрофилов в крови может только врач, путем подсчета их количества в анализе.
Если будет диагностировано увеличение или уменьшение данного показателя, то проводится дополнительная диагностика, на основании результатов которой и будет назначено лечение.
В целом, если палочкоядерные нейтрофилы повышены, причины могут быть как физиологическими, так и патологическими.
Продуцируются палочкоядерные нейтрофилы в костном мозге и составляют наибольшую часть лейкоцитов.
Синтез клетки проходит в несколько стадий:
- миелобласт;
- промиелоцит;
- миелоцит;
- метамиелоцит;
- образуются палочкоядерные нейтрофилы.
Последней стадией развития клетки является образование сегментоядерного нейтрофила.
Необходимо отметить, что палочкоядерные нейтрофилы – это незрелые клетки, поэтому не содержат сегментированного ядра. Форма клетки полностью соответствует ее названию.
Данные незрелые клетки лейкоцитов содержат в себе гранулы следующего состава:
- катионные белки;
- лизоцимы;
- лактоферрин;
- аминопептидазы;
- гидролазы.
После завершения синтеза, клетки попадают в кровоток и там живут около двух суток, после чего преобразуются в сегментоядерные нейтрофилы.
Палочкоядерные и сегментоядерные нейтрофилы отвечают за работу иммунной системы. После уничтожения патогенного организма клетка распадается. Поэтому, чем сложнее протекает заболевание, тем больше молодых нейтрофилов будет продуцироваться.
Процесс развития нейтрофила в организме
Норма у детей данных клеток в анализе крови следующая:
- от рождения и до года – 1-9%;
- от 2 до 7 лет – 2-6%;
- с 8 до 12 лет – 2,5-7%;
- подростковый возраст – 1-7%.
У взрослых количество нейтрофилов в организме должно быть не больше 1%. Однако норма у женщин при беременности несколько выше, но это несущественно. При большом отклонении от допустимого показателя следует обратиться к врачу за консультацией, а не проводить лечение самостоятельно. Как правило, нейтрофилы повышены при беременности не более чем на 1%.
В более редких случаях, но такое все же встречается в медицинской практике, нейтрофилы отсутствуют вовсе. Это является врожденным заболеванием и влечет за собой крайне негативные последствия.
Повышение палочкоядерных нейтрофилов называется нейтрофилез.
Спровоцировать такой патологический процесс могут следующие этиологические факторы:
- инфекционные заболевания;
- вирусные заболевания;
- сахарный диабет;
- нарушение функционирования почек и коры надпочечников;
- аллергические реакции;
- пневмония;
- отит;
- инсульт, инфаркт;
- ревматизм;
- паразитарное заболевание, в том числе и в кишечнике;
- кожные хронические заболевания;
- доброкачественные и злокачественные опухоли;
- анемия;
- масштабные ожоги;
- абсцесс, флегмоны;
- подагра;
- резкая кровопотеря;
- перенесенные ранее операции;
- реакция на прием лекарственных препаратов.
Палочкоядерные нейтрофилы у ребенка могут быть повышены в следующих случаях:
- неправильное питание, раннее введение прикорма;
- врожденные заболевания кроветворной системы;
- наличие инфекционных детских заболеваний.
Физиологически палочкоядерные нейтрофилы повышены у ребенка могут быть:
- после перенесенного накануне операбельного вмешательства;
- при затяжном инфекционном или воспалительном заболевании;
- при ОРВИ, гриппе, простудах;
- при ослабленной иммунной системе;
- после удаления селезенки, прохождения процедуры переливания крови;
- при неправильном рационе – несбалансированное меню, нехватка витаминов, минералов, микроэлементов;
- постоянные стрессы, сильное нервное перенапряжение.
Кроме этого, увеличение численности данных клеток может быть обусловлено сильным эмоциональным потрясением, интоксикацией организма. В любом случае определить причины, почему, нейтрофилы повышены у взрослого или ребенка, может только врач, путем проведения необходимых диагностических мероприятий.
Если нейтрофилы понижены, то такой процесс называется нейтропенией.
Пониженные палочкоядерные нейтрофилы причины имеют следующие:
- вирусные заболевания;
- тяжелая форма течения бактериальных заболеваний;
- тяжелая интоксикация организма металлами, химическими веществами, токсинами и ядами;
- злокачественные опухоли;
- недостаточное количество витамина В;
- облучение радиоактивными веществами, осложнения после химиотерапии.
Если показатели понижены у ребенка, то причины могут быть такими же, как и у взрослых. Однако, ввиду того что детская иммунная система значительно слабее взрослой, патологический процесс протекает в более тяжелой форме. Определить, почему нейтрофилы понижены, может только врач.
Норма палочкоядерных нейтрофилов определяется при помощи ОАК. В анализе крови проводится подсчет не только нейтрофилов, но и других лейкоцитарных элементов. Только в таком случае можно получить развернутую диагностическую картину.
В анализе крови нейтрофилы обозначение имеют такое:
- NE% – относительное содержание вещества, которое измеряется в процентах;
- NE# – абсолютное содержание вещества.
Повышение нейтрофилов именно по количественному показателю является признаком серьезного заболевания в организме, так как речь идет об увеличении количества клеток в процентах и в единицах.
Также следует отметить, что палочкоядерные нейтрофилы норма для детей или взрослых может отличаться немного в большую или меньшую сторону, что не будет показателем заболевания, особенно если накануне пациент перенес тяжелый инфекционный, бактериальный или вирусный недуг.
Для того чтобы анализ показал достоверные результаты, следует придерживаться некоторых правил прохождения процедуры:
- сдавать кровь нужно в утреннее время и только натощак;
- забор крови делается путем пункции из пальца;
- сдавать анализы нужно в спокойном, эмоциональном состоянии;
- за сутки до прохождения процедуры следует отменить прием медикаментозных препаратов, алкоголь, чрезмерные физические и эмоциональные нагрузки.
Если диагностическими методами будет установлено, что количество нейтрофилов слишком занижено или завышено, то врач может назначить повторное проведение анализа и дополнительное обследование, чтобы установить причину патологического процесса и назначить лечение.
Специфической клинической картины понижение и повышение данных клеток не имеет. Характер симптомов будет зависеть от первопричинного фактора. В том случае, если повышение количества клеток незначительное, то внешнее проявление отклонения от нормы может вовсе отсутствовать.
Собирательный симптоматический комплекс может характеризоваться следующим образом:
- головные боли, головокружение без видимой на то причины;
- нарушение функционирования желудочно-кишечного тракта;
- обострение хронических заболеваний, если таковые есть;
- частые случаи ОРВИ, гриппа, более затяжной процесс выздоровления;
- тошнота и рвота;
- общее недомогание и нарастающая слабость, даже при условии длительного и полноценного отдыха;
- аллергические реакции и повышенная восприимчивость к триггерам.
- Ввиду того что подобная клиническая картина может присутствовать практически при любом заболевании, следует обращаться за медицинской помощью, а не проводить лечение самостоятельно.
- Что касается курса терапевтических мероприятий, то здесь все будет зависеть от первопричинного фактора.
- Лечение может основываться на следующих методах:
- прием медикаментов;
- диетическое питание;
- физиотерапевтические процедуры;
- операция;
- санаторно-курортное лечение.
Общей программы лечения нет, так как понижение или повышение количества клеток не является отдельным заболеванием, поэтому и нет специфических препаратов для устранения именно такого нарушения. Это же самое можно сказать и про народные средства терапии – такие методы могут быть включены в общий курс, но только в качестве дополнения или профилактики.
Контролировать количество нейтрофилов очень важно, так как от этого показателя, как и от других лейкоцитарных элементов, зависит функционирование иммунной системы, поэтому систематически необходимо проходить медицинский осмотр и сдавать анализы.
Анализ крови повышенные сегментоядерные и палочкоядерные
Число Количественное превышение уровня нейтрофилов более, чем на 6 с половиной миллиардов единиц на литр крови у детишек в возрасте старше года однозначно указывает на нейтрофилию.
Если палочкоядерные и сегментоядерные нейтрофилы повышены у ребенка, может быть одно из следующих заболеваний:
- гнойный абсцесс;
- анемия гемолитическая;
- ожог 3-4 степени;
- лейкоз;
- трофическая язва;
- острые воспалительные заболевания (пневмония, ангина, перитонит, отит, сепсис).
Чем большее количество нейтрофилов находится в крови, тем интенсивнее протекание воспалительного процесса. В этом случае требуется немедленная диагностика, которая поможет установить точную причину.
Если же имеет место незначительное превышение красных клеток при неимении явных симптомов недомогания, это не является причиной для беспокойства. Их количество у ребенка может увеличиться от проведенной прививки или от лечения иммуностимулирующими препаратами.
Активные физические нагрузки или серьезные психологические переживания могут стать поводом для таких отклонений.
Повышение у беременных женщин
Обычно нейтрофилы повышены при беременности в крови, это является нормой. Следует принять во внимание, что согласно генетическому коду ребенок, развивающийся в полости матки, является чужеродным организмом в отношении к иммунной системе женщины. Для нейтрализации поступающих токсинов в кровь матери поступает максимальное количество разнообразных форм лейкоцитов.
- С целью благополучного вынашивания ребенка следует регулярно контролировать показатели анализа крови.
- Внезапное повышение количества нейтрофилов может указывать на угрозу преждевременных родов или самопроизвольного выкидыша.
- Высокий уровень выделения в кровь будущей матери токсинов провоцирует гормональный сдвиг, после чего иммунная система пытается самостоятельно устранить угрозу для здоровья женщины.
Повышенные нейтрофилы у взрослого человека
Случается так, что при некоторых состояниях организма нейтрофилы повышены у взрослого. Увеличение числа нейтрофилов от общего количества всех лейкоцитов – это явно выраженный и достоверный признак воспалительного заболевания. Иногда о наличии такого процесса взрослый человек даже не подозревает, но повышенные нейтрофилы в крови будут на это указывать.
Во время исследования уровня нейтрофилов определяется обширность имеющегося воспалительного процесса и делается вывод о состоянии иммунной системы человека. Основные показатели нейтрофилеза выглядят следующим образом:
- Повышение до 10,0 на 109 л – наличие локального, то есть единичного воспаления.
- Повышение до 20,0 на 109 л – наличие обширного воспаления.
- Повышение до 40,0-60,0 на 109 л – наличие генерализованного воспаления, сепсиса.
Сепсис считается весьма опасным состоянием для организма. Очень часто он является осложнением какого-то заболевания инфекционного характера, в частности, пневмонии. Соответственно, к любому заболеванию из разряда инфекционных, необходимо относиться с повышенным вниманием.
Нередко нейтрофилез проявляется как показатель онкологического заболевания. В этом случае анализ крови выявляет огромнее количество незрелых нейтрофилов, которые появляются при метастазах. К сожалению, при онкологии нейтрофилез выявляется далеко не всегда, и считается при этом лишь косвенным доказательством патологии.
Кроме этого, нейтрофилез может сопровождать и другие заболевания, а именно: гангрену, ревматоидный артрит, болезни кожи, инфаркт. Таких заболеваний в списке может оказаться невероятное количество. Определить самостоятельно, по какой причине вдруг начало активно увеличиваться число нейтрофилов в крови просто невозможно.
Когда сегментоядерные и палочкоядерные нейтрофилы повышены в крови, необходимо посетить специалиста и, при возможности, сдать дополнительные анализы.
Для точного определения количества клеток в лейкоцитарной формуле крови нередко требуется проведение повторных исследований, ввиду того, что процентное соотношение может неоднократно меняться даже на протяжении суток.
В некоторых состояниях организма иммунная система с легкостью переходит в спящий режим и не показывает при этом в крови уровень клеток лейкоцитарной формулы.
источник
Почему нейтрофилы повышены у взрослого, о чем это говорит?
Нейтрофилами называется самая многочисленная часть лейкоцитов, чьей задачей является защита человеческого организма от самых разных инфекций. Образуются они в костном мозге.
Как только в организм попадают враждебные, патогенные микроорганизмы, с ними тут же вступают во взаимодействие нейтрофилы: они их поглощают и переваривают, вследствие чего погибают и сами (эта способность называется фагоцитозом). Роль нейтрофилов в борьбе с различными инфекциями (особенно грибковыми и бактериальными) трудно переоценить.
Первым ответом на болезнь и становится повышенное образование нейтрофилов и их скопление в месте развития инфекции. Мы постараемся разобраться, почему нейтрофилы повышены у взрослого, о чем это говорит в каждом конкретном случае.
Какие бывают?
Нейтрофилы по форме ядра делятся на палочкоядерные и сегментоядерные.
- Палочкоядерные – не полностью созревшие клетки; в случае тревоги, костный мозг срочно выбрасывает недоразвитые нейтрофильные лейкоциты в кровь, поэтому завышенный (более 6%) или пониженный показатель палочкоядерных – однозначный повод обратиться к врачу.
- Сегментоядерные – зрелые нейтрофилы, являющиеся основой иммунной системы в лейкоцитарной формуле, их норма у взрослых людей составляет от 30 до 70% от количества всех лейкоцитов.
Основной функцией нейтрофилов является иммунная активность против бактерий. При возникновении в организме бактериальной инфекции у человека, сегментоядерные нейтрофилы первыми участвуют в иммунной реакции. В дальнейшем происходит увеличение количества нейтрофилов за счет палочкоядерных. В этот момент в анализе крови человека и выявляют повышенные палочкоядерные нейтрофилы.
Норма нейтрофилов в крови
Палочкоядерных нейтрофилов должно быть от 1 до 5% от общего числа нейтрофилов, сегментоядерных нейтрофилов должно быть от 40 до 68%. Норма должна быть постоянной, и может колебаться от 45 до 70%. У детей, когда они растут, может увеличиваться количество нейтрофилов в крови.
- новорожденные дети – 5-12/50-70%;
Причины повышения сегментоядерных и палочкоядерных нейтрофилов
Иммунная система человека играет ключевую роль в защите организма от патогенных микроорганизмов, токсинов и продуктов распада собственных тканей.
Практически все инфекционно-воспалительные заболевания сопровождаются изменением лейкоцитарного состава, что хорошо видно в клиническом анализе крови и успешно используется для диагностики заболеваний.
Изменение количества нейтрофилов является одним из самых частых, т.к. именно они являются первичным звеном неспецифического иммунитета.
Повышение нейтрофилов
Если нейтрофилы повышены больше нормы, т.е. это называется нейтрофилез. Для взрослых это более 6,5*109/л, для детей зависит от нормы по возрасту. Повышаться могут как отдельные разновидности нейтрофилов — сегментоядерные и палочкоядерные, так и все одновременно.
Сегментоядерные нейтрофилы
Сегментоядерные нейтрофилы являются основной «ударной силой», т.к. за счет своей зрелости они обладают максимальной фагоцитарной активностью — зрелый нейтрофил способен «поглотить» и «переварить» до 20-30 микроорганизмов. Помимо этого у него более совершенный хемотаксис, благодаря чему он быстро добирается до места воспаления и первым начинает фагоцитоз бактерий и чужеродных частиц.
Появление в организме чужеродных агентов (клеток, частиц) является для нейтрофила сигналом для перехода из крови в поврежденные ткани, после чего начинается процесс усиленной их миграции. «Потери» нейтрофильных гранулоцитов восполняются за счет «пристеночного» пула и депо синусов костного мозга.
- Умеренный инфекционно-воспалительный процесс, как правило, приводит к незначительному повышению сегментоядерных нейтрофилов — до 10 *109/л в абсолютных числах и 75% в относительных числах. Палочкоядерные остаются в пределах нормы или повышены до 7-8%.
- Средней степени воспалительный процесс приводит к повышению обеих категорий нейтрофильных гранулоцитов. Общее повышение их доходит до 20 *109/л. Процент палочкоядерных возрастает до 10-12%.
- Генерализованные инфекции и обширные воспалительные процессы, особенно гнойные, приводят к усиленной мобилизации всех нейтрофилов: в крови повышены и сегментоядерные и палочкоядерные клетки. Одних только зрелых гранулоцитов уже не хватает, поэтому в кровь активно поступают не только недозрелые палочкоядерные клетки, но и совсем юные метамиелоциты и миелоциты. Нейтрофилез в абсолютных числах может достигать до 40,0-60,0*109/л и до 85% в относительных числах. На долю палочкоядерных клеток приходится уже 15-20% и более. Помимо количественных изменений наблюдаются и качественные — появляется токсическая зернистость нейтрофилов.
Выраженный лейкоцитоз в крови с выраженным нейтрофилезом называется лейкемоидная реакция миелоидного типа. Выраженный воспалительный процесс в организме сопровождается не только количественными изменениями, но и качественными.
Так при обширных воспалительных процессах, особенно гнойных, отмечается сдвиг лейкоцитарной формулы влево с появлением в периферической крови незрелых (юных) предшественников нейтрофилов, таких как метамиелоцитов и миелоцитов, а при особо тяжелых и обширных инфекциях и промиелоцитов с миелобластами.
Помимо этого, выраженные интоксикации сопровождаются дегенеративными изменениями гранул нейтрофилов — появлением токсической зернистости.
Палочкоядерные нейтрофилы
Как уже было сказано выше, повышение палочкоядерных нейтрофилов в крови происходит при усиленном расходовании сегментоядерных клеток при выраженных инфекционно-воспалительных процессах. Обычно в таких случаях наблюдается увеличение и тех и других.
Но бывают ситуации, когда в лейкоформуле увеличены только палочкоядерные, а сегментоядерные в пределах нормы. Такая ситуация может возникнуть по причине недостаточного количества зрелых клеток и недостаточнов времени для созревания палочкоядерных нейтрофилов.
Причины нейтрофилеза
Причины повышения нейтрофилов у детей и взрослых:
- Бактериальная инфекция
- Грибковая инфекция
- Ожоги
- Обширные травмы
- Деструктивные изменения в тканях
- Химиотерапия
- Распад опухоли
Физиологическое повышение
Умеренное увеличение количества нейтрофилов в крови может наблюдаться также и при некоторых физиологических состояниях, например при усиленной физической работе, после приема пищи, при сильных психоэмоциональных напряжениях, во время беременности.
У новорожденного ребенка также повышены нейтрофилы — это физиологическое повышение наблюдается на протяжении первых 2-3 дней. Уже к 5-6 дню уровень нейтрофилов и лимфоцитов становится одинаковым, а далее происходит снижение.
Повышенный уровень нейтрофилов у новорожденного ребенка
Всегда ли уместно волноваться если нейтрофилы повышены?
Нейтрофилы (гранулоциты, нейтрофильные лейкоциты) – это клетки лимфоциты, которые встают на защиту организма и ценой собственного существования. Погибая, они мешают распространению инфекции. Наличие серьёзных бактериальных или грибковых инфекций может быть подтверждено анализом крови, согласно которому нейтрофилы повышены.
Узнать количество этих клеток можно по результатам общего анализа крови . В отдельной графе указывается процентное содержание нейтрофилов по отношению к общему количеству лимфоцитов. Чтобы выяснить абсолютное (абс.) значение, уже потребуются навыки начальной математики. Необходимо умножить количество лимфоцитов на процент нейтрофилов и разделить полученную цифру на 100.
Пример: лимфоциты – 6 x 109 клеток на литр, нейтрофилы – 70%.
Абсолютное количество клеток нейтрофилов = 4,2 х109/л. (6 x 109 x 70 / 100 = 4,2 x 109).
Столь же часто количество клеток указывается и в тысячах на один микролитр — тыс./мкл., что оставляет числительную составляющую показателя неизменной в обоих случаях.
Превышение количества нейтрофилов
В диагностических целях интересно не только общее количество нейтрофилов, но и их видовое соотношение, они бывают сегментоядерные и палочкоядерные, также при серьёзных патологиях в кровь могут попасть метамиелоциты и миелоциты.
Необходимо обратить внимание на лимфоциты в общем их количестве: они могут быть понижены, находиться в норме или превышать её. Разберём подробнее причины повышения уровня нейтрофилов, постоянно присутствующих в крови.
Но для начала определим отличия разных форм этих кровяных клеток.
Взрослые клетки гранулоцитов имеют ядро, которое поделено на сегменты, отсюда и название – сегментоядерные.
У клеток, не завершивших созревание, ядро до конца не оформлено и имеет вид палочки – они получили название палочкоядерные.
Повышение общего количества нейтрофилов
Если анализ крови указывает на увеличение количества нейтрофилов, это может быть признаком следующих патологий:
- Бактериальная инфекция, которая сопровождается очаговым или общим (генерализованным) воспалительным процессом. В первом случае это может указывать на инфекцию дыхательных путей или горла, гнойно-воспалительный процесс в ухе, туберкулёз, почечную инфекцию в острой фазе, пневмонию и т. д. Во втором случае – холеру, перитонит, сепсис, скарлатину;
- Процессы, сопряжённые с образованием некротизированных участков. Причины кроются в гангрене, инсульте, инфаркте миокарда, ожогах большой площади;
- Наличие токсинов, напрямую воздействующих на функции костного мозга. В качестве агента может выступать алкоголь или свинец;
- Наличие токсинов бактериального происхождения, без внедрения самой бактерии. Зачастую может быть следствием употребления в пищу консервированных продуктов (бактерии утратили жизнеспособность, а продукты их жизнедеятельности ещё присутствуют);
- Злокачественные опухоли на этапе распада тканей.
Повышение нейтрофилов может также указывать на введение вакцины в недавнем прошлом, период восстановления после перенесённого заболевания инфекционной природы.
Варианты нормы
В некоторых случаях нейтрофильные лейкоциты могут повышаться до уровня 7–8 млрд в одном литре крови и являться нормальным значением. Как правило, такие показатели характерны для беременных.
Может возникать после плотного обеда, быть следствием психологической нагрузки, потрясения или физических занятий.
Анализ, как правило, выполняется несколько раз, для того, чтобы установить истинность его показателей.
Степени превышения
Состояние когда нейтрофилы повышены называют нейтрофилёзом или нейтрофилией. Выделяют несколько стадий процесса. Для их классификации используют абсолютные значения показателей, выраженное в миллиардах клеток в одном литре крови (для удобства применяют значение в степени – 109).
| до 10 | умеренный |
| 11-20 | выраженный |
| 21-60 | тяжёлый |
Чем выше степень нейтрофилии, тем тяжелее проходит процесс в организме.
Повышение сегментоядерных нейтрофилов
Сегментоядерные гранулоциты составляют около 70% количества всех нейтрофилов в крови. Повышение их количества наряду с повышением общего количества лейкоцитов говорит о следующих патологиях:
- Инфекции в организме (энцефалит, заболевания грибковой природы, спирохетоз);
- Заболевания нижних конечностей;
- Наличие злокачественных опухолей;
- Патологии в функционировании мочевыводящей системы;
- Воспалительные явления ревматоидной природы, при подагре, панкреатите, артрите, нарушении целостности тканей;
- Повышение уровня глюкозы в циркулирующей крови.
Повышение палочкоядерных нейтрофилов
Палочкоядерные нейтрофилы могут быть повышены при остром течении инфекционного процесса. Их резкий выброс в кровь предусмотрен иммунной системой в ответ на вторжение чужеродного агента.
И также наблюдается повышение уровня нейтрофилов на начальных этапах заболеваний (при условии, что сегментоядерные нейтрофилы находятся в пределах нормы).
Это обусловлено тем, что за период от 5 до 48 часов происходит их «взросление» и формирование сегментированного ядра из «палочки» – они превращаются в сегментоядерные.
Причины высокого показателя палочкоядерных нейтрофилов:
- Воспаления уха, почек или лёгких;
- Период сразу после хирургического вмешательства;
- Острая реакция кожи в виде аллергии или дерматит;
- Нарушение целостности кожных покровов;
- Травмы внутренних органов и костей;
- Ожоги разной степени тяжести;
- Подагра;
- Ревматоидные явления;
- Опухоль доброкачественной и злокачественной природы;
- Анемия;
- Снижение или увеличение температуры окружающей среды;
- Беременность;
- Сахарный диабет;
- Реакция по типу аллергической на приём лекарственных препаратов;
- Большая кровопотеря;
- Бактериальная инфекция и гнойные заболевания.
Физическая нагрузка, нервное перевозбуждение или повышенный уровень углекислого газа также могут стать причиной того, что в организме нейтрофилы повышены.
Известно, что анализ крови указывает на палочкоядерную нейтрофилию после употребления лекарственных средств типа гепарина. Тот же эффект наблюдается и от лекарств кортикостероидного ряда, адреналина или растительных препаратов на основе наперстянки.
Нейтрофилы повышены так же и в результате отравлений свинцом, ртутью или инсектицидами.
Нейтрофилы повышены на фоне снижения количества лимфоцитов
Выше были рассмотрены варианты, когда уровень лимфоцитов повышается вместе с количеством гранулоцитов. Сейчас разберёмся, почему лимфоциты могут быть понижены при увеличении доли нейтрофилов. Анализ крови может дать такой результат при следующих состояниях:
- Почечная недостаточность;
- Хроническое длительное течение заболеваний инфекционной природы;
- Реакция на проведённое рентгеновское исследование;
- Реакция на курс химиотерапии или лучевого лечения;
- Злокачественные заболевания в терминальной стадии;
- Как результат апластической анемии;
- Длительное использование цитостатиков.
Наблюдается такое состояние (лимфоциты понижены, а нейтрофилы повышены) у женщин при предменструальном синдроме, у взрослого вне зависимости от пола нервном перенапряжении и длительной стрессовой ситуации. В таких случаях повышаются, как правило, сегментоядерные гранулоциты.
Норма нейтрофильных лимфоцитов
Анализ крови в разном возрасте показывает различное количество таких клеток в кровотоке по отношению к общему количеству лимфоцитов. В таблице ниже представлена верхняя граница нормальных показателей. Более высокие числовые значения указывают на то что нейтрофилы повышены.
| до 1 года | 4 | 45 |
| 1 – 6 | 5 | 60 |
| 7 – 12 | 5 | 65 |
| 13 – 15 | 6 | 65 |
| 16 и старше | 6 | 72 |
У детей минимальный уровень палочкоядерных гранулоцитов находится на уровне половины процента. У взрослого нижняя граница палочкоядерных гранулоцитов в норме не бывает ниже 1%.
Сегментоядерные гранулоциты у детей до года понижены, если они недотягивают в относительном значении до 15%, от года до шести – до 25%, до 15 лет – до 35%, у взрослых, у взрослых – до 47%
Мы напоминаем, что всёже не стоит самостоятельно планировать курс лечения на основании анализа крови и другиих исследований, даже после тщательного изучения информации в интернете.
Только врач может оценить результаты: имеет значение не только единовременное уменьшение или увеличение показателей, но и их динамика (сравнение с более ранними результатами).
А также необходимо учитывать уровень других кровяных клеток и результаты иных исследований. Оставьте сложную работу профессионалам.
У ребенка повышены нейтрофилы (сегментоядерные, палочкоядерные): причины
При расшифровке анализа крови ребенка педиатры всегда обращают внимание на уровень лейкоцитов в крови.
Наряду с гемоглобином, этот показатель расскажет немало важного о здоровье малютки (подробнее в статье: каковы нормы гемоглобина у детей до 1 года?).
Завышение лейкоцитов наблюдается при остром воспалительном процессе (ОРВИ, инфекционных заболеваниях), и своевременное выявление причины помогает побороть недуг на ранней стадии.
Лейкоцитарная формула показывает, какие из белых кровяных телец находятся в норме, а количество каких ее превышает. Обычно наблюдается увеличение числа нейтрофилов – наиболее масштабной группы лейкоцитов, за формирование которых несет ответственность костный мозг. Что значит их избыток в лейкоцитарной формуле, и как привести показатель к норме?
Нормальные показатели в детском возрасте
Основная задача нейтрофилов – обнаружение борьба с вирусами и болезнетворными микроорганизмами в крови. В процессе развития эти клетки проходят 3 стадии:
- миелоциты – юные нейтрофилы, которых не обнаружить в нормальной лейкограмме;
- палочкоядерные (палочки) – с несформировавшимся клеточным ядром, похожим на жгут;
- сегментоядерные – это зрелые клетки, наиболее многочисленные по процентному содержанию.
Миелоциты и палочкоядерные остаются в костном мозге, в крови их можно обнаружить в единичном количестве.
Аномально высокое их количество в крови (сдвиг лейкоцитарной формулы влево) – свидетельство тяжелых заболеваний крови, острых инфекционно-воспалительных процессов в организме.
Обнаружив подобную картину, врач назначает тщательное обследование до выявления виновника избытка незрелых лейкоцитов.
Нормальные показатели крови в детском возрасте и у взрослых
Процентное содержание палочкоядерных нейтрофилов зависит от возраста. У новорожденных показатель не превышает 17%, у малышей до 5 лет – 5%, в более старшем возрасте – 6%. Пока малыш растет, его лейкоцитарная формула отличается от взрослых показателей по содержанию нейтрофилов.
Нормальные значения сегментоядерных клеток представлены в таблице:
| Возраст | Процент нейтрофилов в лейкоцитарной формуле |
| Новорожденный | 45-80 |
| 1-12 месяцев | 15-45 |
| 1-12 лет | 25-60 |
| Подростковый период | 40-65 |
| Старше 16 лет | 47-72 |
Почему наблюдается нейтрофилез – повышение нейтрофилов?
Повышение уровня показателей в лейкоцитарной формуле называется нейтрофилез. Чем сильнее источник его возникновения воздействует на организм малыша, тем выше будет уровень лейкоцитов.
Они могут быть завышены во время длительных умственных и физических нагрузок или после еды.
Наиболее часто высокие показатели говорят о заболевании или воспалительном процессе, избыточный процент клеток напрямую зависит от стадии болезни.
Нейтрофилез вызывают:
- разрушение оболочек лейкоцитов;
- сахарный диабет;
- острая кровопотеря;
- пищевые, медикаментозные отравления;
- опухолевые процессы;
- большие по площади ожоги;
- аллергические реакции;
- ряд медикаментов, в частности – гормональных;
- послеоперационный период;
- вирусные и бактериальные инфекции;
- аппендицит, артрит, бронхит, пневмония и другие заболевания, связанные с воспалительными процессами в организме (см. также: симптомы приступа аппендицита у детей 3-х лет).
В младенчестве и детском возрасте наблюдается доброкачественная хроническая нейтропения. Часто она не сопровождается никакими симптомами, и врачи принимают тактику наблюдения.
Крайне редко (1-2 случая на миллион человек) встречается циклическая нейтропения. В этом состоянии наблюдается периодическое снижение уровня нейтрофилов в крови с последующим естественным восстановлением.
Подобное явление передается с генами и не влияет на качество жизни. Еще одно наследственное заболевание – синдром Костмана. В этом случае нейтрофилы не достигают зрелых форм, что приводит к серьезному ослаблению иммунитете.
В современном мире такое состояние корректируется медикаментозно.
ЧИТАЕМ ТАКЖЕ: почему у ребенка до года понижены нейтрофилы?
Сдвиги лейкоцитарной формулы
Лейкоцитарная формула показывает нормальное, повышенное или пониженное содержаниебелых кровяных телец. При завышении нормальных значений врачи рассматривают, какие клетки (палочкоядерные или сегментоядерные) спровоцировали ситуацию. Различают два состояния:
- Сдвиг лейкоцитарной формулы влево. В этой ситуации увеличены значения палочкоядерных и присутствуют юные клетки, которых быть не должно. Подобную картину наблюдают при инфекционно-воспалительных процессах, ожогах, анемии, лейкозе, умственных переутомлениях и серьезных нагрузках (см. также: симптомы лейкоза у детей с фото). Самостоятельно определить, вызывает ли подобный сдвиг серьезные проблемы со здоровьем, невозможно. Необходим строгий врачебный контроль.
- Сдвиг формулы вправо (встречается реже). Наблюдается много сегментоядерных клеток, что свидетельствует о снижении способности организма противостоять вирусам и бактериям. В этой ситуации идет плохое обновление крови. Сдвиг вправо вызывают болезни почек, прием антибиотиков, стероидных гормонов, анемия, лучевая болезнь. Диагностировать причину помогают аппаратные методы (УЗИ, томография), дополнительные клинические исследования.
ЧИТАЕМ ТАКЖЕ: подробная расшифровка анализа крови и показателей у детей
Также анализ позволяет выявить токсическую зернистость нейтрофилов, которая наблюдается при тяжелых и затяжных заболеваниях.
Зернистость нейтрофильных гранулоцитов обусловлена токсическим воздействием вредоносных микроорганизмов, под влиянием которых разрушаются ядра клеток.
Нейтрофилы при этом становятся неполноценными и являются для врача маркером тяжелой инфекции и даже сепсиса (при дополнительных симптомах).
Соотношение лимфоцитов и нейтрофилов
Нейтрофилы и лимфоциты находятся в определенной связке. Нейтрофилы – опора клеточного иммунитета. Они первыми обнаруживают вредоносные бактерии и начинают борьбу с ними.
Выполнив работу и уничтожив «врага», они гибнут и образуют гной, который выводится впоследствии моноцитами («дворниками» в крови).
Лейкоцитоз с повышением нейтрофилов в формуле связан с понижением в это время лимфоцитов (рекомендуем прочитать: причины лейкоцитоза в крови у ребенка).
ЧИТАЕМ ТАКЖЕ: по каким причинам повышены моноциты у грудничка?
В дальнейшем с понижением нейтрофилов идет подъем уровня лимфоцитов, которые включаются в работу. Все события, которые происходят в организме, отражаются в лейкоцитарной формуле.
Повышение нейтрофилов достигает 70%, при этом объем лейкоцитов составляет 30%. Наоборот, при низком содержании нейтрофилов повышены лейкоциты.
Когда острые процессы завершаются, процентное соотношение выравнивается, и врачи называют такую формулу крови «спокойной».
ЧИТАЕМ ТАКЖЕ: повышенные тромбоциты в крови у ребенка – что это значит?
Что делать при обнаружении нейтрофилеза?
О том, что лейкоциты у ребенка повышены, педиатр обязательно предупредит маму во время расшифровки анализов крови. Придется сдать повторный анализ, поскольку результаты могут быть искажены по таким причинам:
ИНТЕРЕСНО: о чем могут говорить низкие лейкоциты в крови у ребенка?
- Беспокойство крохи, спешка, негативная атмосфера во время забора крови. Маме с малышом следует подойти в лабораторию заранее, чтобы спокойно дождаться своей очереди. Не стоит пугать ребенка рассказами о том, что ему придется терпеть боль («ты храбрый, будет больно, но терпи»). Опытные лаборанты берут кровь практически безболезненно.
- Ребенок что-то скушал или выпил перед сдачей анализа. Кровь важно сдать натощак, именно поэтому большинство анализов назначают на первую половину дня. Новорожденных и грудничков не стоит морить голодом, однако его стоит накормить за 2-3 часа до манипуляций. Пить можно всем детям, но только воду: она не влияет на процентный уровень лейкоцитов.
- Физические нагрузки перед забором крови. Следует спокойно провести время перед походом в лабораторию и во время ожидания своей очереди в медицинском заведении. Ребенок не должен физически утомляться накануне, бегать и прыгать в поликлинике.
ЧИТАЕМ ТАКЖЕ: лимфоциты в крови у ребенка: причины высоких показателей
Если при повторном заборе крови родители учли все рекомендации, но результат показывает отклонения в лейкоцитарной формуле, назначают дополнительное обследование.
Первоначально врач исключает наличие очага воспаления в организме, при необходимости отправляет на серьезное обследование. При выявлении причины нейтрофилеза ребенок проходит медикаментозное лечение. Грамотно подобранная терапия в совокупности с умеренной физической активностью и оздоровительными мероприятиями гасит очаг воспаления, и показатели анализов возвращаются в норму.